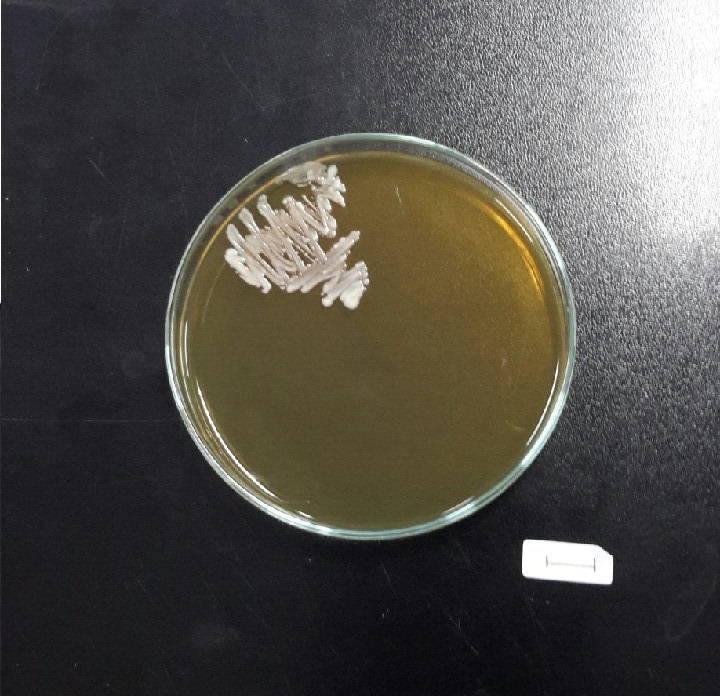

Лямблии в чашке Петри: Фотографии под микроскопом

:format(png)/cdn.vox-cdn.com/uploads/chorus_image/image/49217367/Screen_Shot_2016-04-01_at_5.49.38_PM.0.0.png)















/Mardonov.files/1.png)

















Раздел: Природная галерея